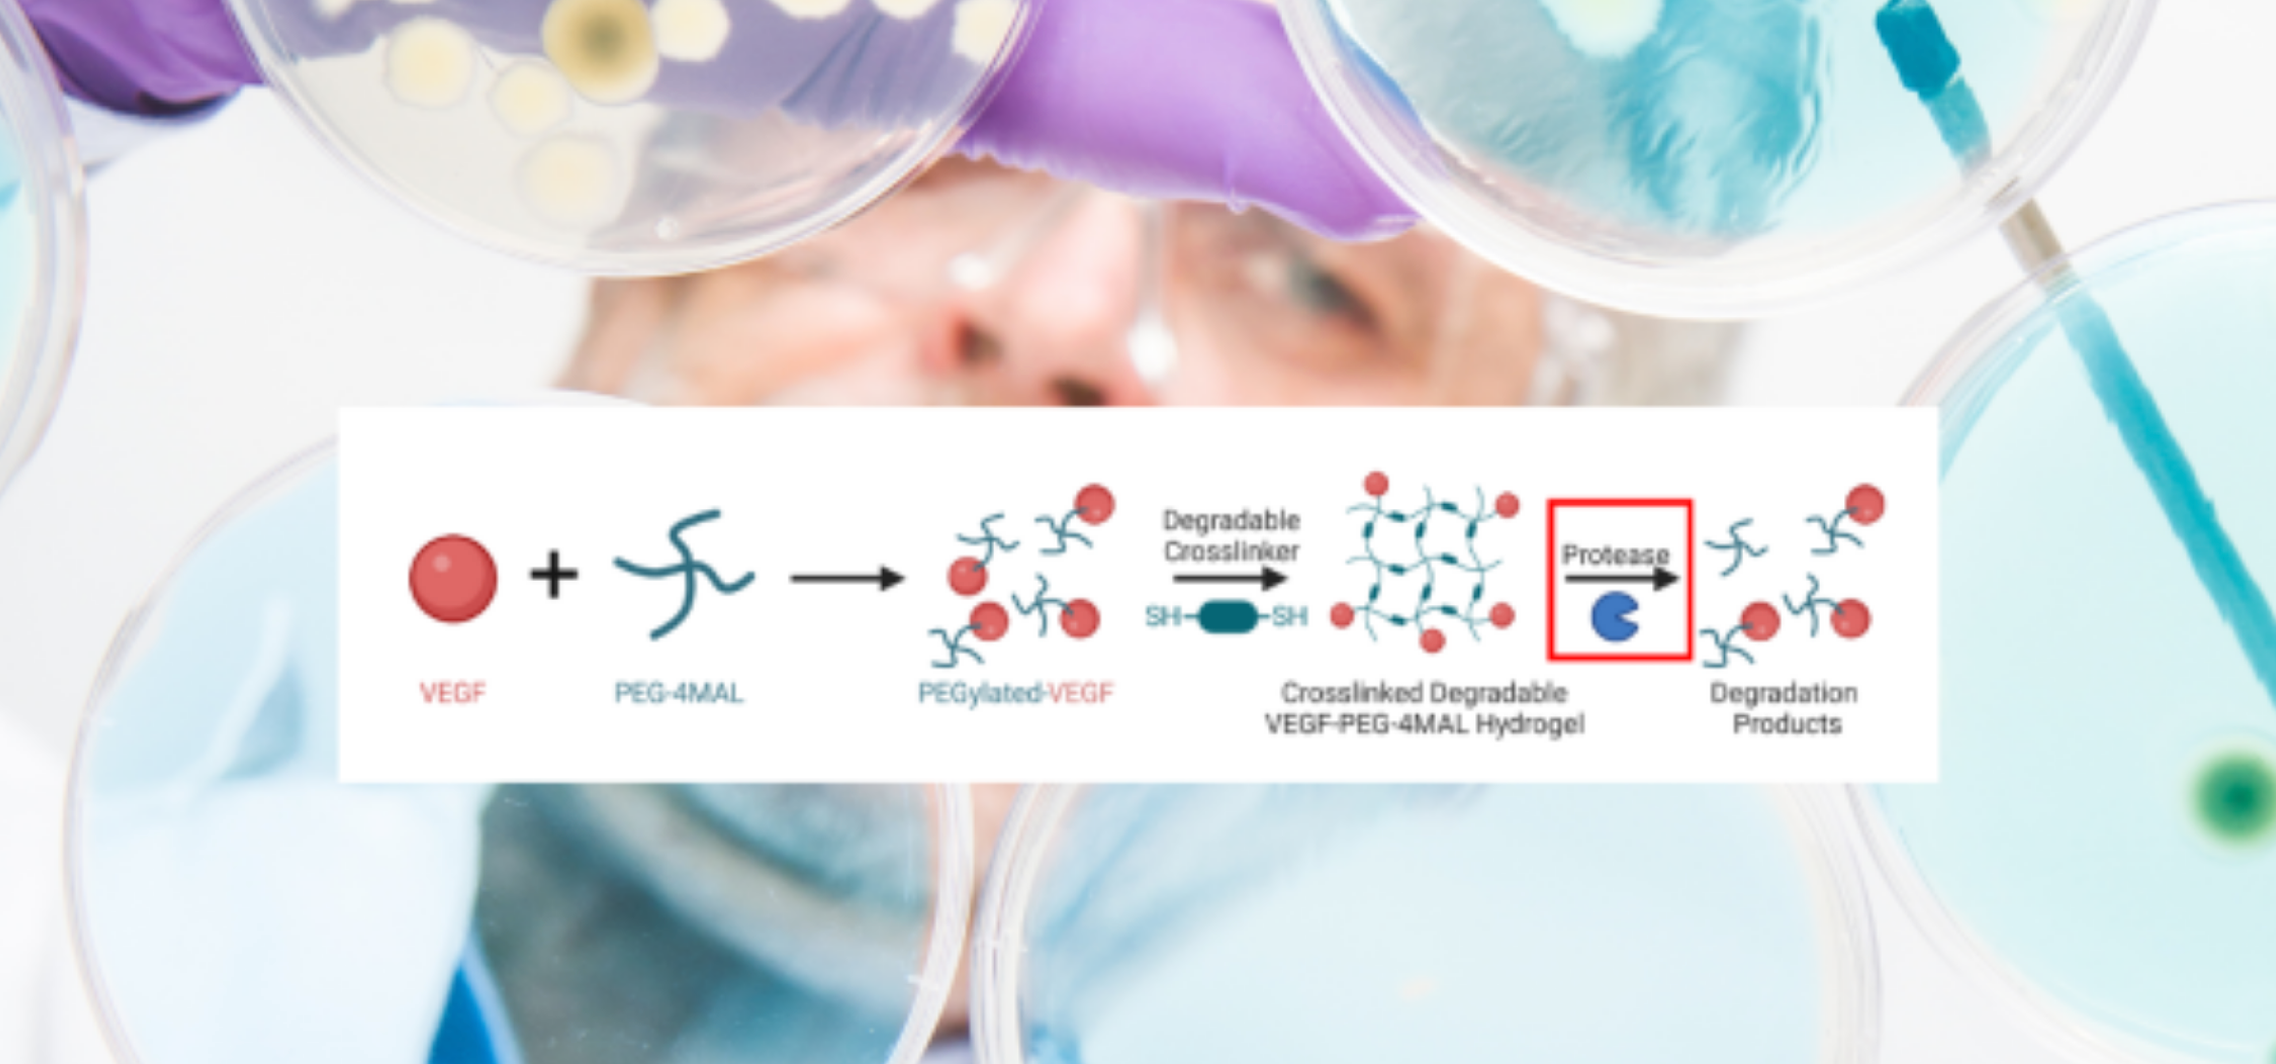
image of a research with text and equation to represent science

Building connections to support commercialization
The Office of Technology Licensing (OTL) delivers resources and support to demystify the commercialization process, delivering the goal of seamlessly moving innovative intellectual property (IP) to market. By expanding access to all faculty and students, we grow the IP pipeline to ensure more research is commercialized through startups and industry partnerships. With our robust licensing program, Georgia Tech moves towards becoming a number one commercialization campus nationwide.